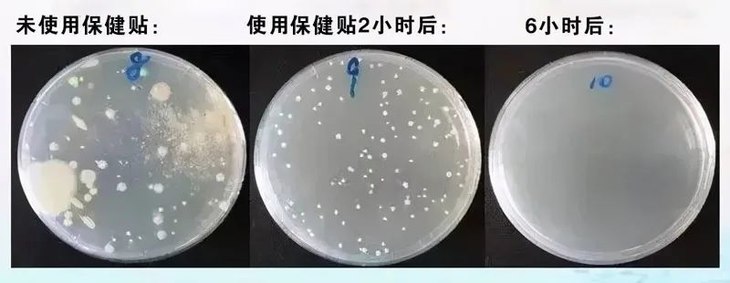

过年吃的喝的开心了,但是这小肚子,将军肚、啤酒肚,过年回来,肚子都是一晃一晃的~

再加上熬夜玩牌,搞的最近肠胃功能下降,腹泻、胀气,不消化,浑身难受……


消化不良,胃中的食物不消化,垃圾毒素堆积,酸臭腐败的味道从胃里翻上来,怎么刷牙都没用……

大量油腻,冷饮入体,打乱肠胃菌群平衡,下损伤肠胃吸收,腹泻口臭 ,上侵害皮肤,长疮长痘!

这不,我这几天皮肤也不好了,三天冒俩痘,皮肤也暗沉没气色,不养胃真的不行了!
如果长时间不调整,大量有害菌在肠胃腐烂发酵、凝结,肠胃菌群彻底破坏,蔓延成胃炎、胃溃疡等!
排毒、养胃迫在眉睫!


在东汉名医张仲景《伤寒论》中记载:
“白头翁为君,黄连,黄柏共为臣药,秦皮为佐使药,专克热毒灼烧肠胃导致的肠胃失和!”

相传东汉时期常年战乱,百姓流离失所,很多人肠腹俱损,绞痛难耐 ,一天拉10多次,更有甚者,拉到脱水而亡……

当时朝廷派去名医张仲景,凭借一碗汤药医好!
10分钟止泻,1个时辰腹痛消失,就是用的这碗“白头翁汤”!

张仲景在收录《伤寒论》记载:白头翁汤专治,热毒熏灼肠胃气血,热毒阻滞气机,则腹痛里急后重。
腹痛、腹泻便秘,皆为肠胃问题,白头翁汤均有奇效,1天肠胃和缓,便秘腹泻消失;5天养肠壮胃,10天老胃病根除。

因白头翁汤的奇效,现代研究团队,沿袭千年古方,萃取12味天然植萃,运用现代先进技术,
经过12000次临床改进,历经3年,研制出外敷肠胃“金钟罩”——肠胃保健贴

中药萃取,透皮吸收,药力直达肠胃,排出肠胃垃圾毒素!当天断绝口臭,恢复闻得见!


7天肠毒全清,腹胀腹痛全消!
中医认为,人的肚脐内联全身经络,用神阙穴渗透直达,脐疗直接吸收,杀菌保健效果提高3倍以上!

1个月缓解10年老胃炎!根除肠胃毒素堆积,全方位修复肠胃黏膜,缓解胃炎、胃痛、消化不良等问题!

12味天然草本精粹,消灭肠道有害菌,从里到外恢复身体,下调肠胃,上养皮肤!

用了2周,肠胃舒服了,之前蹲在厕所蹲半个小时还是稀稀拉拉的,现在3分钟轻松结束,干净利索再也没有拉不尽的的感觉,小肚子都变小了。

每天晚上贴上保健贴,一整晚肚子都很舒服,肠道中的宿便和毒素减少了,脸上的豆豆也都消失了,素颜原相机拍摄下,都能看出脸上干净多了!

不单单是我用的效果好,用过的人都说好!
@云南洪女士:用了肠胃保健贴,真的从里到外修复肠胃问题,之前舌苔厚腻,口臭严重,用了3天肠胃贴,清楚的看到舌苔变得健康红润,口臭全消!

@广东的汪先生:之前去医院查出来糜烂性胃炎,孩子给买了肠胃保健贴,最开始就感觉,胃口好了,吃饭消化也好了,胃胀胃疼也少了很多,用了2个月,医院一检查,胃炎竟然也好了!

为了大家的肠胃健康,今天特发粉丝惊喜福利!
39元/盒
拍2发3!
拍3发5!!
拍4发7!!!
买的越多送的越多,全家一起用起来,全家肠胃健康,全身舒适!
肠胃平和主要靠有害菌和有益菌的平衡,一旦有害菌猖獗,不但会消化不良,还会免疫力低下,更易生病!

保健贴采用千年古方,纯草本精华经过穴位渗透,1贴清肠胃毒素,恢复胃粘膜,从根源去除老胃病!

保健贴精华经过神阙穴,脐疗给药,10秒直达肠胃深处,快速识别细菌,捆绑缠绕,将细菌统统消灭!

《内经》认为神阙主治五脏六腑之疾。脐疗给药不受胃酶干扰破坏,不经肝脏代谢,易吸收、见效快。

保健贴为了完美吸收药力,其中加入远红外磁粉,3倍吸收草本精华,消灭病毒细菌,形成肠胃保护罩!


肠胃毒素降低,肠胃平稳,腹痛腹泻全走开,24小时长效口气清新,养胃健肠,提高肠胃免疫力!

肠胃不好的基本都是大肚子,肠道里面都是毒素,大肚腩不消化,每天贴1贴,1个月大肚腩像泄气一样变小了,整个人都瘦了,脸上也干净白皙很多!

肠道毒素消失,消化正常,再也不胀气难受,口臭直接消失,用了专业口气测试仪器,用了肠胃保健贴之后,从巨臭的4,变成口气清新的0!

肠胃是身体最大的藏毒器,肠胃不好全身都差!
肠胃中的细菌、病毒会随着血液流遍全身,最明显就会导致皮肤变差,暗黄、色斑长满脸!

肠胃保健贴精华渗透,10秒杀菌开始,12小时长效抑菌,实验表示,6小时后,肠道菌群下降80%!
细菌滋生的慢,腹痛腹泻消失,血液也干净了!28天皮肤水润干净,色斑暗黄淡化!

下调肠胃,上养皮肤,28天年轻10岁!
四川的邹女士:经常肠胃不好,腹泻小肚腩还大,朋友推荐的肠胃保健贴,先不说肠胃好了,小肚子没了,最惊喜的就是,脸上色斑暗黄全都淡了,用了一个月,看我脸嫩的,比做医美效果好多了!

肠胃保健贴出自东汉名医张仲景的《伤寒论》,传承千年,经过现代专家验证,去肠毒、养肠胃俱佳!

每一味药材更是经过精心挑选,养肠去肠毒,和胃舒缓!



白头翁为君,《本经》中记载,白头翁清热解毒,凉血止痢,对肠胃失和有奇效!

黄连泻火解毒,燥湿厚肠,为治痢要药,其中的黄连素具有抑菌作用,是细菌性胃肠炎、痢疾等消化道问题的特效药。

黄柏清下焦湿热,黄柏、黄连共助君药清热解毒,尤能燥湿治痢,共为臣药

《本草纲目》记载秦皮苦涩而寒,清热解毒而兼以收涩止痢,抑制肠道有害菌的同时养护肠胃,为佐使药。
另辅以荜茇、五倍子、胡椒、苍术、艾草等,共12味草本精华,远离腹痛腹泻、消化不良!

12味草本浓缩,众多中医专家匠心研制,反复调试、实验,专为肠胃不适人群研制出10秒见效保健贴!

植物萃取,温和无刺激,一贴可用12小时,晚上贴上,一夜安眠,告别肠胃不适!

想要知道产品好不好,一定要看看用过的人怎么说,来看看随机截图的某平台的评价:

为了大家的肠胃健康,今天特发粉丝惊喜福利!
39元/盒
拍2发3!
拍3发5!!
拍4发7!!!
扫码关注“小来生活馆”公众号
即可领取5元无门槛优惠券!
除此之外,还有超值好礼!
关注公众号回复数字“88”
免费领取牙膏一只哦!
▼点击下方关注
